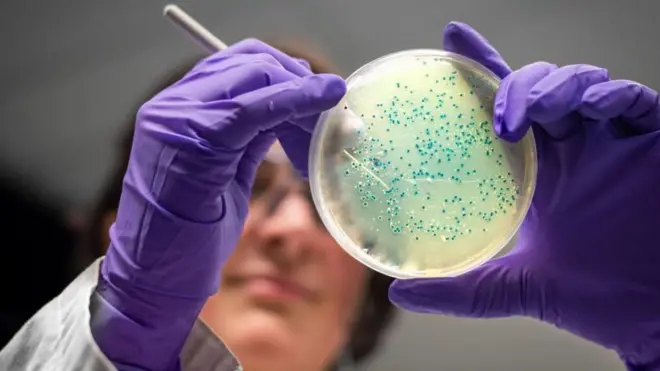
బాక్టీరియా

ఆర్ఎస్ఎస్పై మోదీ ప్రశంసలు.. దేనికి సంకేతం?

ఫొటో సోర్స్, Getty Images
- రచయిత, రాఘవేంద్రరావ్
- హోదా, బీబీసీ ప్రతినిధి
స్వాతంత్ర్య దినోత్సవం సందర్భంగా ఎర్రకోట నుంచి వరుసగా పన్నెండోసారి చేసిన ప్రసంగంలో ప్రధానమంత్రి నరేంద్ర మోదీ గత పదకొండేళ్లగా ఎప్పుడూ మాట్లాడని విషయం ఒకటి ప్రస్తావించారు.
రాష్ట్రీయ స్వయంసేవక్ సంఘ్ (ఆర్ఎస్ఎస్) గురించి ప్రధాని మాట్లాడారు. ప్రపంచంలోనే అతిపెద్ద ఎన్జీవోగా ఆర్ఎస్ఎస్ను అభివర్ణించారు. సంఘ్ వందేళ్ల ప్రయాణాన్ని ప్రధాని ప్రశంసించారు. సేవ, అంకితభావం, వ్యవస్థీకరణ, సాటిలేని క్రమశిక్షణ ఈ సంస్థ గుర్తింపు అని కూడా ప్రధాని మోదీ అన్నారు.
కొంతకాలంగా భారతీయ జనతా పార్టీకి, సంఘ్కు మధ్య అనేక అంశాలపై భేదాభిప్రాయం ఉందన్న వాదనలున్నాయి.
ఈ పరిస్థితుల్లో ప్రధాని మోదీ తన స్వాతంత్ర్య దినోత్సవ ప్రసంగంలో ఆర్ఎస్ఎస్ గురించి ప్రస్తావించడం ప్రాధాన్యం సంతరించుకుంది.


ఫొటో సోర్స్, Getty Images
సంఘ్ గురించి ప్రధాని మోదీ ఏమి చెప్పారు?
తన 103 నిమిషాల సుదీర్ఘ ప్రసంగంలో.. 82వ నిమిషంలో ఆర్ఎస్ఎస్ గురించి ప్రస్తావించారు ప్రధానమంత్రి మోదీ.
''ఇవాళ నేను చాలా గర్వంగా ఒక విషయం గురించి మాట్లాడాలనుకుంటున్నా. వందేళ్ల క్రితం ఓ సంస్థ పుట్టింది. దాని పేరు రాష్ట్రీయ స్వయంసేవక్ సంఘ్. దేశానికి వంద సంవత్సరాల సేవ అన్నది చాలా గర్వకారణమైనది. చరిత్రలో సువర్ణాక్షరాలతో లిఖించదగ్గది.
"వ్యక్తిగత అభివృద్ధితో జాతి నిర్మాణం అనే సంకల్పంతో, తల్లి భారతి సంక్షేమమే ధ్యేయంగా, వంద సంవత్సరాలుగా మాతృభూమి సంక్షేమం కోసం తమ జీవితాలను అంకితం చేశారు" అని మోదీ వ్యాఖ్యానించారు.
"సేవ, అంకితభావం, వ్యవస్థీకరణ, సాటిలేని క్రమశిక్షణ, ఇదే దాని గుర్తింపు. ఒక విధంగా, రాష్ట్రీయ స్వయంసేవక్ సంఘ్ ప్రపంచంలోనే అతిపెద్ద ఎన్జీవో. దీనికి వందేళ్ల అంకితభావ చరిత్ర ఉంది.
ఈ వందేళ్ల ప్రయాణంలో భాగస్వామ్యులైన వలంటీర్లందరినీ ఇవాళ ఎర్రకోట ప్రాకారాల నుంచి గౌరవంగా గుర్తుచేసుకుంటున్నా. రాష్ట్రీయ స్వయంసేవక్ సంఘ్ ప్రయాణంపై దేశం గర్విస్తోంది. ఇది మనకు కలిగించే స్ఫూర్తి కొనసాగుతూనేఉంటుంది'' అని ప్రధాని మోదీ అన్నారు.

ఫొటో సోర్స్, ani
సంఘ్ను ప్రశంసించడాన్ని ఎలా చూడాలి?
కొంతకాలంగా బీజేపీ, సంఘ్ మధ్య సంబంధాలు సాధారణంగా లేవని భావిస్తున్నారు.
2024 లోక్సభ ఎన్నికల్లో బీజేపీకి మెజారిటీ రాకపోవడానికి అతిపెద్ద కారణం, ఆ పార్టీ ఆశించిన స్థాయిలో ఆర్ఎస్ఎస్ క్షేత్రస్థాయి కార్యాచరణ లేకపోవడమేనని భావిస్తున్నారు.
గత లోక్సభ ఎన్నికల సమయంలో బీజేపీ అధ్యక్షులు జేపీ నద్దా ఓ ప్రకటన చేశారు. బీజేపీకి సామర్థ్యం ఉందని, ఆర్ఎస్ఎస్ అవసరం పార్టీకి లేదని నద్దా వ్యాఖ్యానించారు.
నద్దా ప్రకటనపై స్పందించిన ఆర్ఎస్ఎస్ ఇది అంతర్గత వ్యవహారమని, ఇలాంటి అంశాలను బహిరంగ వేదికలపై చర్చించబోమని తెలిపింది.
నద్దా ప్రకటన సొంతంగా చేసింది కాదని, ఆ ప్రకటన ఆయనతో ఇప్పించారని సంఘ్లోని చాలా మంది భావించినట్లు రాజకీయ విశ్లేషకులు చెప్పారు.
బీజేపీలో తన పాత్ర గురించి కొత్త ఆలోచన వస్తున్నట్టు అదే సమయంలో సంఘ్ భావించడం ప్రారంభించింది.
నీలాంజన్ ముఖోపాధ్యాయ ఒక రచయిత, రాజకీయ విశ్లేషకులు, జర్నలిస్ట్. బాబ్రీ మసీదు కూల్చివేత, ఆర్ఎస్ఎస్కు చెందిన ప్రముఖులపై ఆయన పుస్తకాలు రాశారు.
''ఎవరి పేరు చెప్పకుండానే బీజేపీ నాయకత్వానికి వ్యతిరేకంగా మోహన్ భగవత్ స్పష్టమైన వ్యాఖ్యలు నేరుగా చేయడం అందరికీ గుర్తుంది. నరేంద్ర మోదీ పేరు ప్రస్తావించకుండా 'ఆదర్శ సేవకుడు ఎవరు' అనేది మొదలుకుని అన్ని విషయాల గురించి ఆయన మాట్లాడారు'' అని నీలాంజన్ ముఖోపాధ్యాయ గుర్తుచేశారు.
లోక్సభ ఫలితాల తర్వాత, సీట్లు తగ్గినప్పుడు, మరోసారి సంఘ్తో తన సంబంధాలను మెరుగుపరుచుకోవడానికి బీజేపీ ప్రయత్నించింది.
ఆ తర్వాత మాత్రమే బీజేపీ, ఆర్ఎస్ఎస్ మధ్య సయోధ్య ప్రారంభమైంది. హరియాణా, మహారాష్ట్ర, దిల్లీ ఎన్నికలలో ఈ మేరకు సమన్వయం కనిపించింది.

ఫొటో సోర్స్, Getty Images
‘మోదీకి ఆర్ఎస్ఎస్ గుణపాఠం నేర్పింది’
ఈ పరిస్థితుల్లో స్వాతంత్ర్య దినోత్సవ ప్రసంగంలో సంఘ్ను ప్రశంసించడం వెనుక మోదీ ఉద్దేశం ఏమిటనే ప్రశ్న తలెత్తుతుంది?
''ప్రధాని మోదీకి ఆర్ఎస్ఎస్తో కాస్త తీపి-కాస్త చేదు అనుబంధం ఉంది. గత అన్ని స్వాతంత్ర్య దినోత్సవ ప్రసంగాలలో, ఆర్ఎస్ఎస్ గురించి మోదీ ప్రస్తావించలేదు. సంఘ్ మద్దతు అన్నది తమ హక్కు అన్నట్టుగా బీజేపీ భావించింది. మోదీకి మద్దతు ఇవ్వడం తప్ప ఆర్ఎస్ఎస్కు వేరే మార్గం లేదని వారనుకున్నారు'' అని రచయిత్రి, రాజకీయ విశ్లేషకురాలు రాధిక రామశేషన్ అభిప్రాయపడ్డారు.
''తన వాక్చాతుర్యాన్ని, ఆకర్షణ శక్తిని, నిర్వహణా సామర్థ్యాన్ని ఎవరూ ప్రశ్నించలేరని ఆయన భావించారు. కానీ గత లోక్సభ ఎన్నికల్లో మోదీకి ఆర్ఎస్ఎస్ గుణపాఠం నేర్పింది. ఎందుకంటే సంవత్సరాలుగా క్షేత్రస్థాయిలో చురుగ్గా పనిచేస్తున్న ఆర్ఎస్ఎస్ కార్యకర్తలు అదే ఉత్సాహాన్ని చూపించలేదు'' అని రాధిక రామశేషన్ చెప్పారు.
అప్పటినుంచి ఆ సంబంధాన్ని మెరుగుపరచుకోవడానికి మోదీ చాలా ప్రయత్నించారని రాధిక రామశేషన్ అంటున్నారు. ''ఉదాహరణకు, కుల గణనను ప్రకటించడానికి ఒక రోజు ముందు మోహన్ భగవత్ను కలిసిన మోదీ ఆయన గ్రీన్ సిగ్నల్ పొందిన తర్వాతే దానిని ప్రకటించారు'' అని ఆమె తెలిపారు.

ఫొటో సోర్స్, Getty Images
ఆర్ఎస్ఎస్కు ఏం చెప్పదలుచుకున్నారు?
స్వాతంత్ర్య దినోత్సవ ప్రసంగంలో సంఘ్పై మోదీ ప్రశంసలను అర్థం చేసుకోవడానికి, కొన్ని సంవత్సరాల నేపథ్యాన్ని అర్థం చేసుకోవడం ముఖ్యమని నీలాంజన్ ముఖోపాధ్యాయ అన్నారు.
''భారతీయ జనతా పార్టీని ఎలా నడుపుతారనే దానిపై ఒకటిన్నరేళ్లగా ఆర్ఎస్ఎస్ నాయకత్వంతో మోదీ పోరాడుతున్నారు. ఆయన బీజేపీని నిరంకుశంగా, లేదా ఏకపక్షంగా నడుపుతారా లేదా గతంలో ఏకాభిప్రాయంపై ప్రాధాన్యత ఇచ్చిన విధంగా నడుపుతారా?
బీజేపీ చరిత్రలో మొదటిసారి, ఇంతకాలం పాటు పార్టీ అధ్యక్షుడి ఎన్నిక జరగలేదు. దానిపై ఆర్ఎస్ఎస్తో సమస్య ఉండడంతో దాని గురించి ఎవరూ ప్రస్తావించడం లేదు.
బీజేపీ స్వేచ్ఛను కోరుకుంటోంది, సంఘ్ ఏకాభిప్రాయం ఉండాలంటోంది. ప్రస్తుతం ఉపరాష్ట్రపతిని ఎన్నుకోవాలి. ఈ విషయంలో తమను సంప్రదించాలని, కనీసం కొన్ని పేర్లు తాము సూచించాలని సంఘ్ భావిస్తోంది'' అని నీలాంజన్ ముఖోపాధ్యాయ్ చెప్పారు.
ఈ సమస్యలన్నింటినీ సమతుల్యం చేసే ప్రయత్నంలో భాగమే ప్రధాని మోదీ సంఘ్ను ప్రశంసించడమని ముఖోపాధ్యాయ విశ్లేషించారు.
''ఆర్ఎస్ఎస్కు దాని పరిమితులు ఉన్నాయని కూడా ఆయన చెబుతున్నారు. సంఘ్కి అలాంటి సర్టిఫికెట్లు ఇస్తానని చెబుతున్నారు. అదే సమయంలో సంప్రదింపులు అవసరం లేదని తాను భావించే విషయాలపై సంప్రదించబోనని కూడా ఆయన చెబుతున్నారు'' అని ముఖోపాధ్యాయ అభిప్రాయపడ్డారు.

ఫొటో సోర్స్, Getty Images
వచ్చే ఎన్నికలను దృష్టిలో పెట్టుకునా?
కొన్ని నెలల్లో బిహార్ అసెంబ్లీ ఎన్నికలు జరగనున్నాయి. వచ్చే ఏడాది అసోం, పశ్చిమ బెంగాల్, తమిళనాడు, కేరళ, పుదుచ్చేరిలలో ఎన్నికలు జరగనున్నాయి.
సంఘ్ను బహిరంగంగా ప్రశంసించడానికి, రాబోయే ఎన్నికలకు ఏదైనా సంబంధం ఉందా?
ఆగస్టు 15న చేసిన ప్రసంగంలో ఆర్ఎస్ఎస్కు ప్రధాని స్నేహహస్తం చాచడం చాలా ముఖ్యమైన విషయమని రాధికా రామశేషన్ అన్నారు.
"ఇప్పుడు బిహార్ ఎన్నికలు వస్తున్నాయి. వచ్చే ఏడాది ఇంకా చాలా ముఖ్యమైన ఎన్నికలు జరగనున్నాయి. తమిళనాడు లేదా బిహార్లో ఆర్ఎస్ఎస్ ఎంత శక్తివంతమైనదో చెప్పడం కష్టంగానీ బీజేపీకి హాని కలిగించే సామర్థ్యం దానికుంది.
ఆర్ఎస్ఎస్ కోరుకుంటే, అది ఆటను మలుపు తిప్పగలదు. మాటల ద్వారా వారు చాలా పనిచేస్తారు. వారు సానుకూలంగా లేకుంటే బీజేపీకి కష్టమవుతుంది.
కాబట్టి ఆర్ఎస్ఎస్ను సంతోషంగా ఉంచడం మోదీకి చాలా ముఖ్యం. బీజేపీకి ఓట్లను రాబట్టగల ప్రధాన ఆకర్షణాశక్తి తానే అన్న భ్రమలో ఇప్పటికే మోదీ ఉంటే ఆ భ్రమను బద్ధలు కొట్టాలని ఆర్ఎస్ఎస్ అనుకుంటోందన్నది నా అభిప్రాయం'' అని ఆమె విశ్లేషించారు.
స్వాతంత్ర్య దినోత్సవ ప్రసంగంలో సంఘ్ గురించి ప్రస్తావించడం ద్వారా, బిహార్లో ఆర్ఎస్ఎస్ తనను మోసం చేయకుండా, తనకు మరిన్ని సమస్యలను సృష్టించకుండా మోదీ చూసుకుంటున్నారని నీలాంజన్ ముఖోపాధ్యాయ అన్నారు. అదే సమయంలో పార్టీ అధ్యక్షుడిని, ఉపరాష్ట్రపతిని తానననుకున్నవారిని ఎంచుకోవడానికి ఆర్ఎస్ఎస్ అంగీకరించాలని మోదీ కోరుకుంటున్నారని తెలిపారు.
ఆర్ఎస్ఎస్పై ప్రశంసలు బీజేపీ, ఆర్ఎస్ఎస్ మధ్య క్వి ప్రో కో (ఏదైనా పొందడానికి బదులుగా ఏదైనా ఇవ్వడం)కూడా సూచిస్తాయని రాధిక రామశేషన్ అన్నారు.
"బీజేపీ తదుపరి అధ్యక్షుడి గురించి మీడియాలో ఊహాగానాలు వస్తున్నాయి కానీ జేపీ నద్దా పదవిలో కొనసాగుతున్నారు. కాబట్టి ఆర్ఎస్ఎస్ కోరుకునే వ్యక్తులు మోదీకి అవసరం లేదని నేను భావిస్తున్నాను. అక్కడ కొంత సమస్య ఉంది. రాబోయే రోజుల్లో బీజేపీ అధ్యక్షుడు ఎవరు అవుతారనేది చాలా ముఖ్యం. ఉపరాష్ట్రపతి ఎవరవుతారనేదానికన్నా బీజేపీ అధ్యక్ష పదవి ఎవరికి దక్కుతుందనేదే ముఖ్యమైంది అని నేను భావిస్తున్నాను" అని ఆమె అన్నారు.
"తనకు నచ్చిన వ్యక్తిని బీజేపీ ఉపరాష్ట్రపతిని చేయగలదు. ఆర్ఎస్ఎస్ కోణంలో బీజేపీ అధ్యక్ష పదవి చాలా ముఖ్యమైనది కాబట్టి తనకు నచ్చిన వ్యక్తి బీజేపీ జాతీయ అధ్యక్షుడు కావాలని సంఘ్ కోరుకుంటుంది.
మోదీ, అమిత్ షాలకు ఆమోదయోగ్యం కాని వ్యక్తిని ఆర్ఎస్ఎస్ ఎంపిక చేస్తుందని నేను అనుకోను. ఈ సమయంలో ఆర్ఎస్ఎస్ కూడా అంత రిస్క్ తీసుకోవాలనుకోదు. కాబట్టి రాబోయే రోజుల్లో కొంత రాజీ ఫార్ములా ఖచ్చితంగా కనిపిస్తుంది" అని ఆమె చెప్పారు.

ఫొటో సోర్స్, ani
మోదీ వ్యాఖ్యలపై విమర్శలెందుకు?
రాష్ట్రీయ స్వయంసేవక్ సంఘ్పై వినిపించే ప్రధాన విమర్శలలో ఒకటి, అది బ్రిటిష్ రాజ్కు వ్యతిరేకంగా భారత స్వాతంత్ర్య ఉద్యమంలో చురుగ్గా పాల్గొనలేదని.
ఎర్రకోట నుంచి స్వాతంత్ర్య దినోత్సవ ప్రసంగంలో ఆర్ఎస్ఎస్ను ప్రధాని మోదీ ప్రశంసించడంపై ఈ కోణంలో కూడా విమర్శలు వినిపిస్తున్నాయి.
"స్వాతంత్ర్య దినోత్సవ ప్రసంగంలో ఆర్ఎస్ఎస్ను కీర్తించడం స్వాతంత్య్ర పోరాటాన్ని అవమానించడమే" అని ఎంఐఎం అధ్యక్షుడు అసదుద్దీన్ ఒవైసీ ఎక్స్లో విమర్శించారు.
'' ఆర్ఎస్ఎస్, దాని సైద్ధాంతిక మిత్రులు బ్రిటిష్ వారికి మద్దతు ఇచ్చారు. వారెప్పుడూ స్వాతంత్ర్య పోరాటంలో పాల్గొనలేదు, బ్రిటిష్ వారిని వ్యతిరేకించిన దానికంటే ఎక్కువగా గాంధీని ద్వేషించారు" అని అసదుద్దీన్ ఓవైసీ ఆరోపించారు.
"ఎర్రకోట నుంచి మొదటి ప్రసంగం 1947లో కాదు, 1948లో జరిగింది" అని నీలాంజన్ ముఖోపాధ్యాయ అన్నారు.
ఈ ప్రసంగం నాటికి దేశం పరిస్థితి ఎలా ఉందంటే, గాంధీజీ హత్య తర్వాత భారత్లో విషాద వాతావరణం నెలకొంది. ఆ సమయంలో నిషేధిత సంస్థల్లో ఆర్ఎస్ఎస్ ఒకటి. సంస్థ ప్రధాన నాయకులు జైలులో ఉన్నారు. ప్రధానమంత్రి జవహర్లాల్ నెహ్రూ తన ప్రసంగంలో గాంధీజీ హత్య గురించి ప్రస్తావించారు.
గాంధీని ఎవరు చంపారు? 1930లలో రాష్ట్రీయ స్వయంసేవక్ సంఘ్లో పనిచేసిన నాథూరామ్ గాడ్సే. ఉరితీయడానికి ముందు నాథూరామ్ గాడ్సే చేసిన చివరి పని ఆర్ఎస్ఎస్ ప్రార్థన ఆలపించడం. కాబట్టి
ఆయన ఉద్దేశం ఏమిటో మీకు అర్థమవుతుంది.
మనం ఇంక వేరే ఏమీ అర్థం చేసుకోవలసిన అవసరం లేదు. స్వాతంత్ర్య దినోత్సవం రోజు జాతినుద్దేశించి ప్రసంగించడం అనే సంప్రదాయం ప్రారంభమైన చోట ఇప్పుడు అక్కడి నుంచి రాష్ట్రీయ స్వయంసేవక్ సంఘ్ గురించి ప్రచారం చేశారు. వారిని ప్రశంసించారు. ఇది విచారకరమైనది. కోపం తెప్పించేంది. ఎందుకంటే ఇది మన దేశం ఆలోచనను తిరస్కరించడం లాంటిది'' అని నీలమ్ ముఖోపాధ్యాయ విశ్లేషించారు.
స్వాతంత్ర్యానికి ముందు ఆర్ఎస్ఎస్ పాత్రను కూడా నీలాంజన్ ముఖోపాధ్యాయ ప్రశ్నించారు.
"రెండవ ప్రపంచ యుద్ధం, క్విట్ ఇండియా ఉద్యమంలో ఆర్ఎస్ఎస్ బ్రిటిష్ వారికి మద్దతు ఇచ్చింది. భారత జాతీయ ఉద్యమాన్ని బలోపేతం చేసిన విధానం ఇదేనా? భారత జాతీయ ఉద్యమంలో, స్వాతంత్ర్య పోరాటంలో ఆర్ఎస్ఎస్ పాత్ర ఏంటి?" అని ఆయన ప్రశ్నించారు.
"బ్రిటిష్ సామ్రాజ్యాన్ని కుదిపేసిన మూడు ముఖ్యమైన ఘటనల్లో మొదటిది సహాయ నిరాకరణ ఉద్యమం, రెండోది, దండి మార్చ్, దాంతో ముడిపడి ఉన్న శాసనోల్లంఘన ఉద్యమం, మూడోది క్విట్ ఇండియా ఉద్యమం. మైక్రోస్కోప్ ద్వారా చూసినా, ఈ మూడింటిలో దేనిలోనూ మీరు ఆర్ఎస్ఎస్ ఉనికిని గుర్తించలేరు'' అని ఆయన చెప్పారు.

ఫొటో సోర్స్, Express/Archive Photos/Getty Images
75 ఏళ్ల డెడ్లైన్పై చర్చేంటి?
ఎర్రకోట నుంచి సంఘ్పై ప్రధాని మోదీ ప్రశంసలు ఇంకో విషయానికి కూడా ముడిపడి ఉన్నాయి.
75 ఏళ్లు నిండిన నాయకులు తమ పదవులను వదిలివేయాలని ఆర్ఎస్ఎస్ చీఫ్ మోహన్ భగవత్ కొన్ని రోజుల క్రితం అన్నారు.
సెప్టెంబర్ నెలలో మోదీకి 75 ఏళ్లు నిండుతాయి కాబట్టి ఈ మాటల ద్వారా మోదీకి మోహన్ భగవత్ ఏదో చెబుతున్నారా అనే సందేహం కలిగింది.
75 ఏళ్లు దాటిన తర్వాత, నాయకులు ఎన్నికల్లో పోటీ చేయకపోవడం లేదా తమ పదవులను వదిలివేయడం బీజేపీలో చాలా ఏళ్లగా జరుగుతోంది.
కానీ మోదీ అలా చేస్తారా?
మోదీ తన పదవీకాలాన్ని పూర్తి చేస్తారని, ఆయన ప్రధానమంత్రిగా కొనసాగడంపై బీజేపీలో ఎలాంటి గందరగోళం లేదని హోంమంత్రి అమిత్ షా గతంలోనే అన్నారు.
''ప్రధానమంత్రి ప్రసంగంలో అత్యంత ఆందోళనకరమైన అంశం ఎర్రకోట ప్రాకారాల నుంచి ఆర్ఎస్ఎస్ గురించి మాట్లాడడం - ఇది రాజ్యాంగ, లౌకిక గణతంత్ర స్ఫూర్తిని స్పష్టంగా ఉల్లంఘించడం. వచ్చే నెలలో ఆయన 75వ పుట్టినరోజుకు ముందు ఆ సంస్థను సంతృప్తి పరచడానికి చేసిన తీవ్ర ప్రయత్నం తప్ప మరొకటి కాదు'' అని కాంగ్రెస్ నాయకుడు జైరామ్ రమేశ్ ఎక్స్లో విమర్శించారు.
"జూన్ 4, 2024 నాటి సంఘటనల తర్వాత నిర్ణయాత్మకంగా బలహీనపడిన ప్రధానమంత్రి, సెప్టెంబర్ తర్వాత తన పదవీకాలాన్ని పొడిగించుకోవడానికి ఇప్పుడు పూర్తిగా మోహన్ భగవత్ దయపై ఆధారపడి ఉన్నారు. వ్యక్తిగత, సంస్థాగత లాభం కోసం స్వాతంత్ర్య దినోత్సవం వంటి జాతీయ సందర్భాన్ని రాజకీయం చేయడం మన ప్రజాస్వామ్య విలువలకు చాలా హానికరం" అని జైరామ్ రమేశ్ వ్యాఖ్యానించారు.
"వచ్చే నెలలో మోహన్ భగవత్ కు 75 ఏళ్లు నిండుతాయి, కొన్ని రోజుల తర్వాత మోదీకి కూడా 75 ఏళ్లు నిండుతాయి. మోదీ ఈ నియమాన్ని అందరిపైనా ప్రయోగించి ఉంటే, దానిని ఆయన తనపై ఎందుకు ప్రయోగించుకోలేకపోతున్నారనేది చట్టబద్ధమైన ప్రశ్న" అని రాధికా రాబశేషన్ అంటున్నారు.
"మోహన్ భగవత్ తన పదవిలో కొనసాగుతారా లేదా మరొకరిని సర్సంఘ్చాలక్గా నియమిస్తారా అనేది కూడా చూడాలి. ఈ సందర్భంలో, ఇద్దరి మధ్య కొంత రాజీ కుదురుతుందని, మోదీ బహుశా తన స్థానంలోనే ఉంటారని నేననుకుంటున్నా'' అని రాధికా రామశేషన్ అన్నారు.
(బీబీసీ కోసం కలెక్టివ్ న్యూస్రూమ్ ప్రచురణ)
(బీబీసీ తెలుగును వాట్సాప్,ఫేస్బుక్, ఇన్స్టాగ్రామ్, ట్విటర్లో ఫాలో అవ్వండి. యూట్యూబ్లో సబ్స్క్రైబ్ చేయండి.)